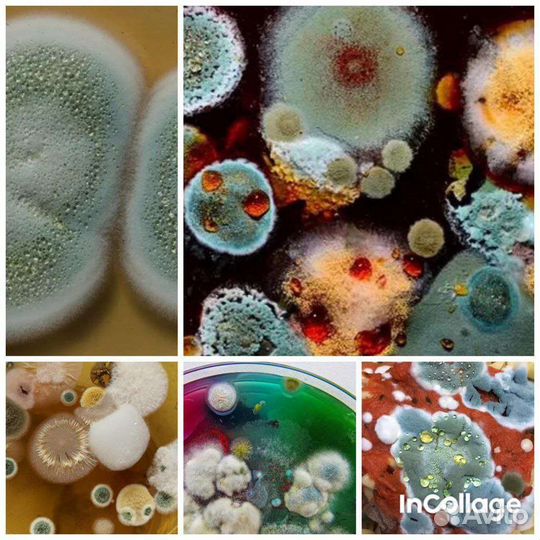
Уничтожение удаление плесени и грибка

Уничтожение тараканов клопов чешуйниц блох мышей
700 руб.
Уничтожение тараканов клопов чешуйниц блох мышей
ОБЕЗЗАРАЖИВАНИЕ ПОМЕЩЕНИЙ ЛЮБОЙ ПЛОЩАДИ и любой степени зараженности препаратами премиум класса, без запаха и не оставляющими следов на мебели, поручнях, одежде.
Уничтожим тараканов, блох, клопов, чешуйниц, пауков, муравьёв, мышей, крыс, плесень, запахи, вирусы в помещениях любого типа (жилые/ нежилые).
ОБРАБАТЫВАЕМ УЧАСТКИ ЛЮБОГО ТИПА от клещей, борщевика, кротов, мышей, землероек, ос, шершней, комаров, мошки, сколопендры, мух, пауков, шашелей, муравьёв, от любых жуков и т.д.
Обрабатываем дома, квартиры, коттеджные посёлки, загородные участки, водоёмы, лесопарковую зону, дворовые территории, прилегающие территории к кафе, сельскохозяйственные объекты, хостелы, офисные помещения, места общественного питания, складские помещения – объекты любого типа!
ГАРАНТИЯ на предоставляемые услуги до 3-х лет
Мы работаем 24/7 КРУГЛОСУТОЧНО
Химический и Физический метод обработки.
Обрабатываем профессиональным оборудованием:
Генератор холодного тумана
Генератор горячего тумана
Генератор сухого тумана
Мотопомпы
Озонаторы
Мастера используют ПРЕМИУМ ПРЕПАРАТЫ, которые не наносят вреда здоровья людям и животным.
Оперативный выезд в течении получаса!
Строго КОНФИДЕНЦИАЛЬНО
Звоните!
уничтожение клопов, удалить тараканов, уничтожение борщевика, морить тараканов, избавиться от клопов, избавиться от сколопендры, дезинфекция в помещении, уничтожить тараканов, уничтожить блох, избавиться от тараканов в квартире, вывести клопов, бороться с клопами, удалить муравьёв, дезинсекция от насекомых, устранение тараканов, дезинфекция от клещей, травля тараканов, избавление от тараканов, избавиться от кротов, обработать хостел от тараканов, уничтожить шершней, обработать участок от тли, вызов мастера на дезинфекцию, обработать дом от муравьев, обработка от тараканов, травля тараканов, обработка от плесени, уничтожить плесень, вывести блох, вывести сколопендру, уничтожить муравьёв, обработка от клопов, удаление запахов, ликвидация клопов, уничтожение насекомых, удалить клопов, борьба с клопами, выведение тараканов, таракан квартира, удалить клопов, удалить тараканов, удалить блох, уничтожение клещей, обработка от клещей, обработка от блох, удаление запахов, выведение запахов, обработать участок от ос, уничтожить мышей, обработка от клещей, стоимость дезинфекции участка, обработать участок от комаров, борщевик сосновского скосить, средства от комаров, избавиться от землероек, морить клещей, потравить клопов туманом, гербициды от борщевика, клещи на даче, акарицидная обработка
Объвление найдено на сайте avito.ru. Перейдите по ссылке для покупки или просмотра более подробной информации